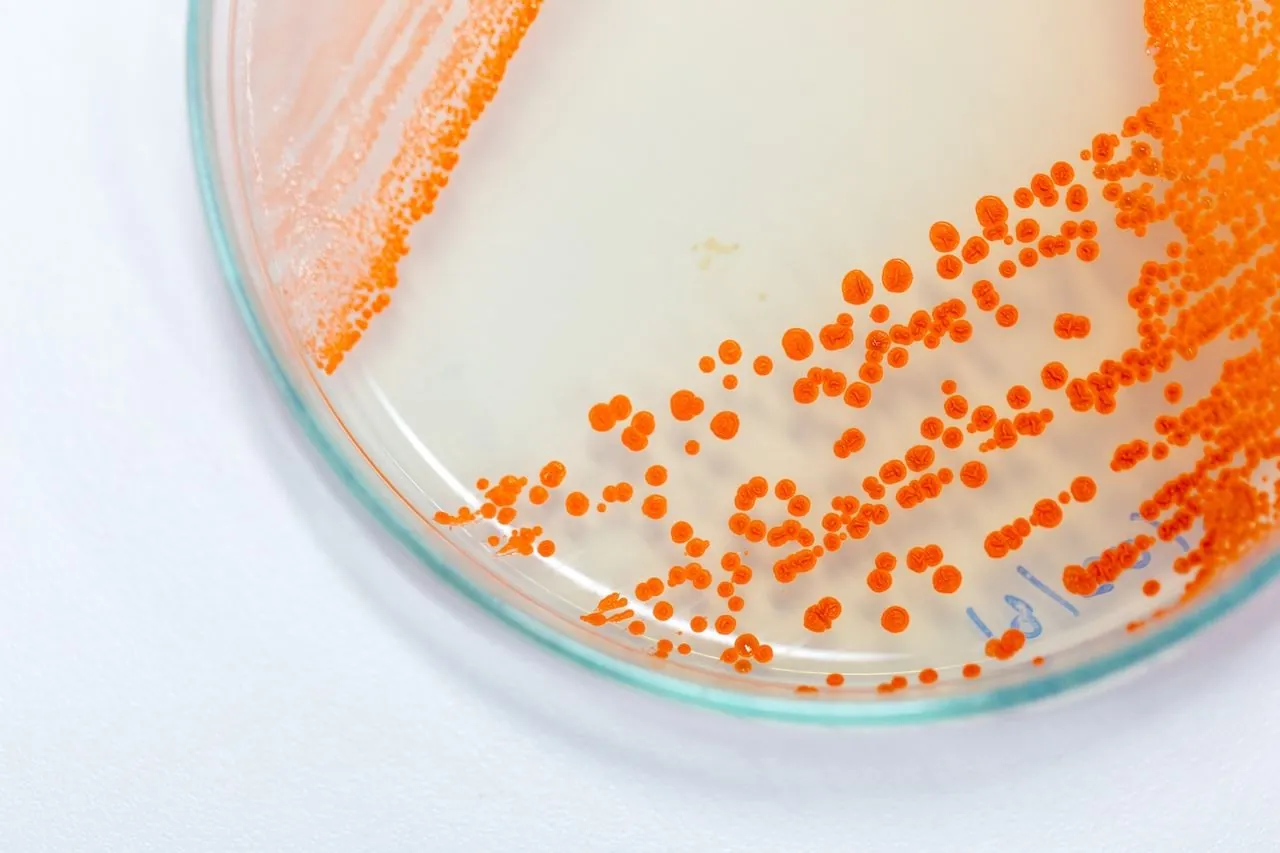
What is Pink Mold: Causes and Removal Tips, image size:1280x853
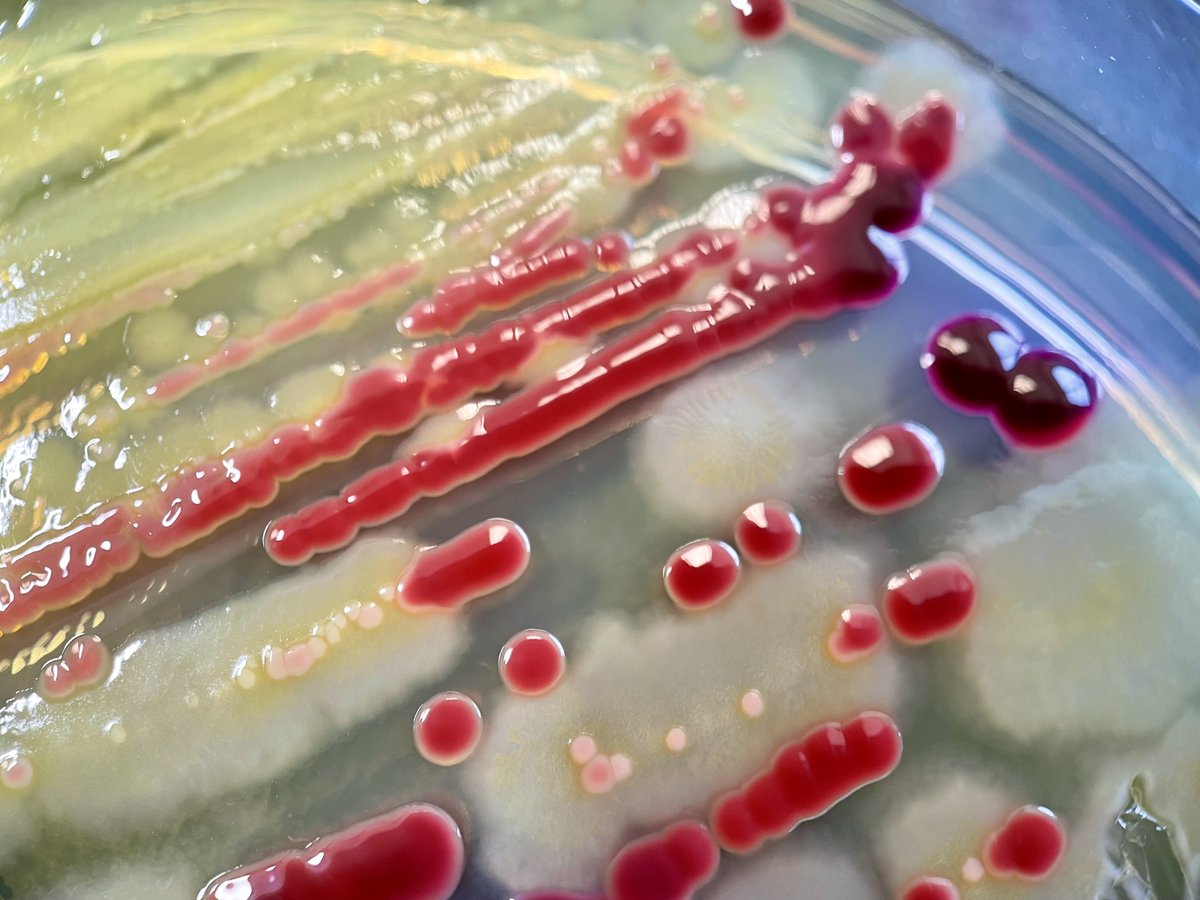
Serratia marcescens and Escherichia coli isolated from soft tissue  infection. Serratia marcescens produces a red pigment, prodigiosin.  Prodigiosin has antimicrobial properties, potentially giving Serratia a  competitive advantage against other bacteria ..., image size:1200x900
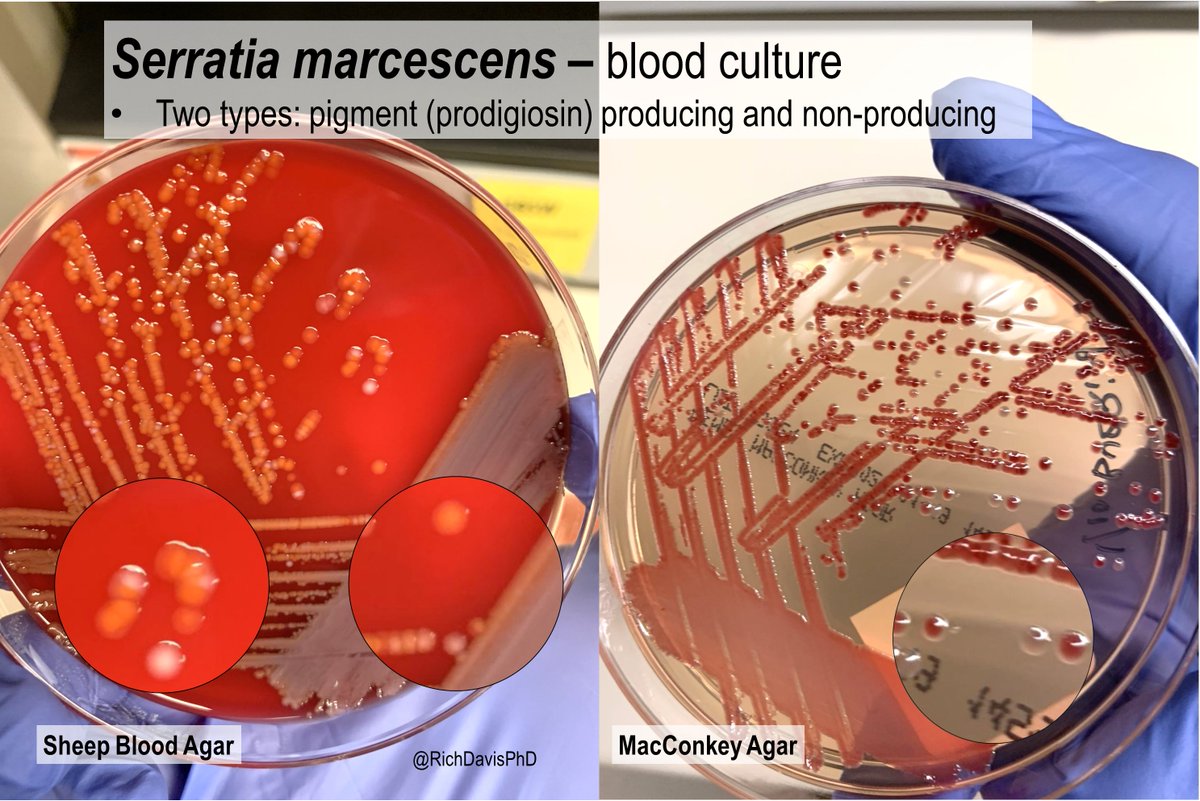
Frontiers | Transcriptional factor OmpR positively regulates prodigiosin  biosynthesis in Serratia marcescens FZSF02 by binding with the promoter of  the prodigiosin cluster, image size:1200x801
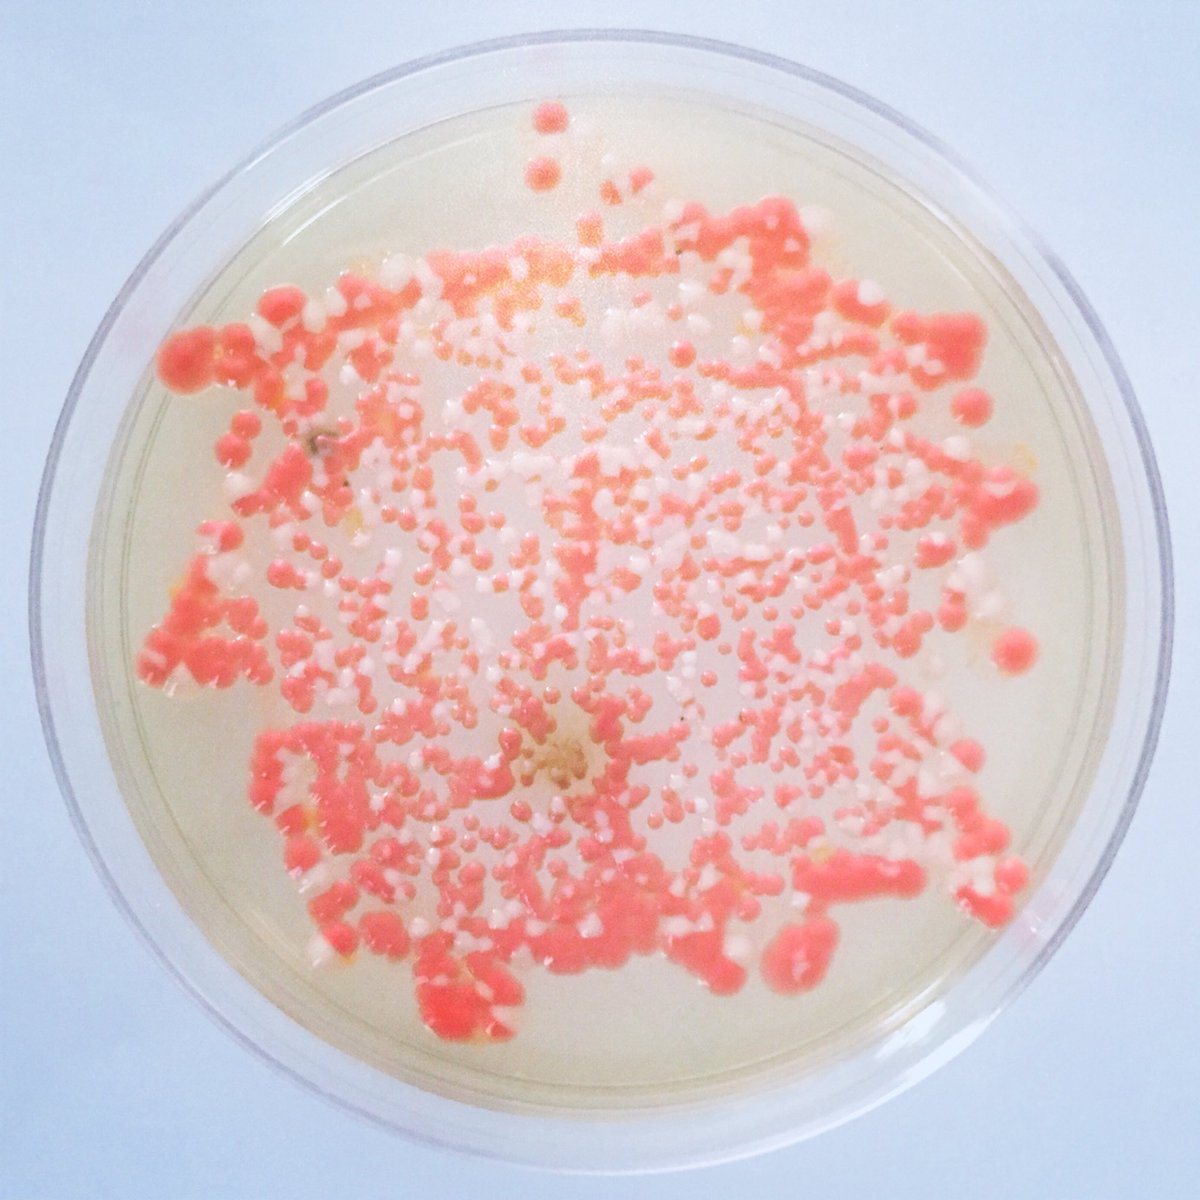
Cutaneous Serratia marcescens infection in two dogs - Park - 2024 - Journal  of Small Animal Practice - Wiley Online Library, image size:1200x1200
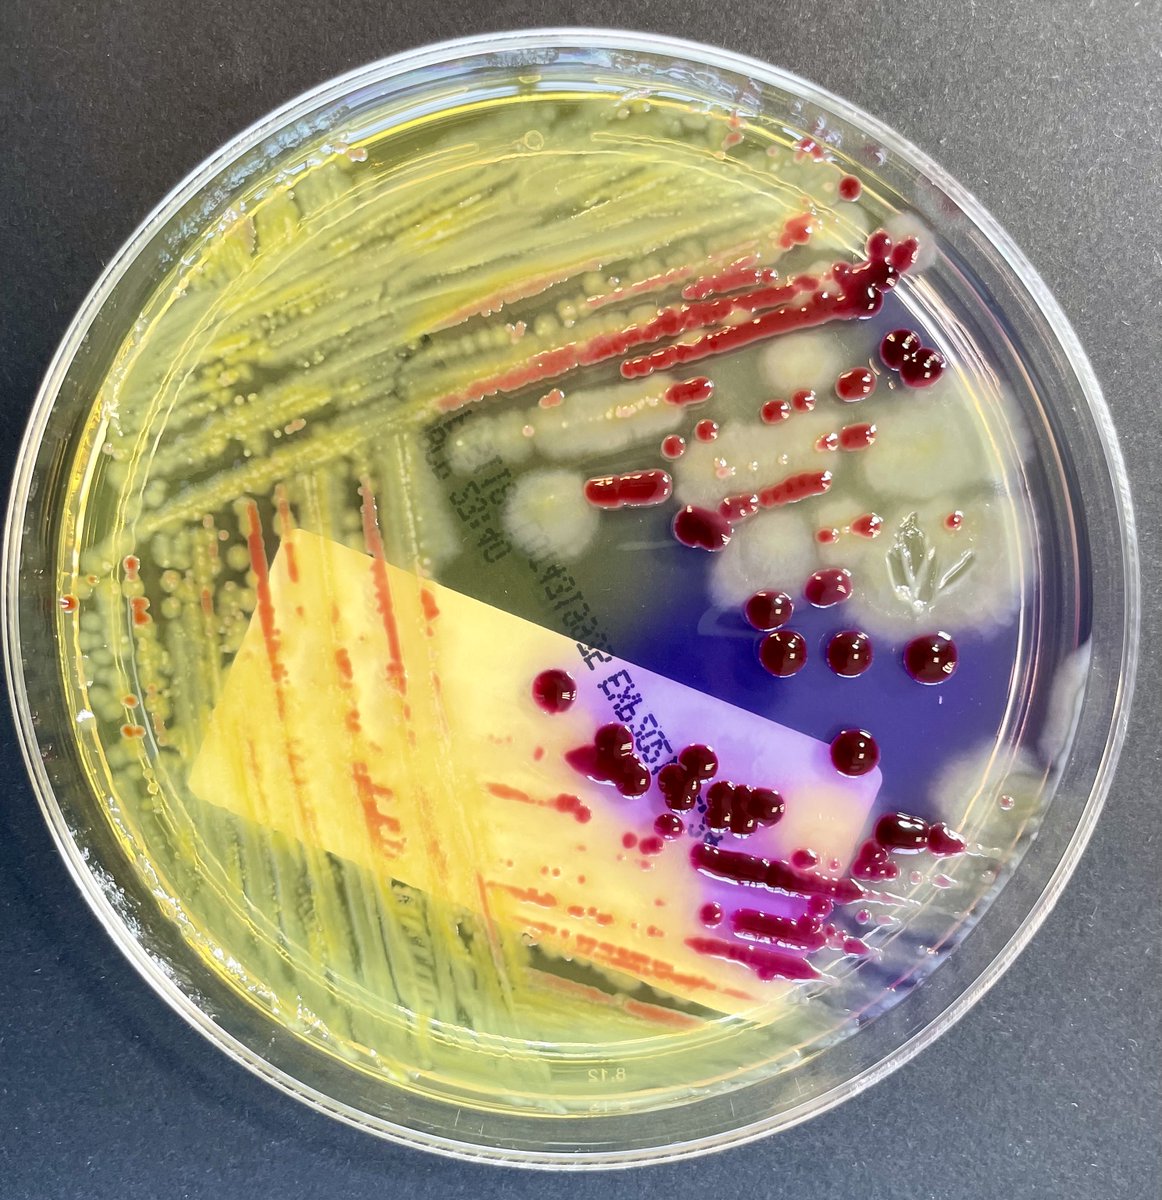
Bacteria colors — Akna Márquez, image size:1162x1200

Nwredhead
Gallery · April 2025
Serratia Marcescens Bacteria
Serratia Marcescens Bacteria Serratia marcescens Red Pigment Bacteria Line Two Color 67431581 Vector Art at Vecteezy


Serratia marcescens: Bacteria, Infection, Causes \u0026 Treatment
image size: 800x1588

Serratia marcescens - Wikipedia
image size: 2327x2149

Serratia - Wikipedia
image size: 1373x1371

Serratia Marcescens is Inactivated by Germicidal UV-C Light
image size: 1630x856

Serratia Marcescens Bacteria Gram-negative Rod-shaped Bacteria Stock Illustration 1038065014 | Shutterstock
image size: 1500x1101

Video: Serratia marcescens | Osmosis
image size: 1280x720

Serratia Marcescens Bacteria Gram-negative Rod-shaped Bacteria Stock Illustration 1036394287 | Shutterstock
image size: 1500x1101

Frontiers | Transcriptomic Analysis Reveals Competitive Growth Advantage of Non-pigmented Serratia marcescens Mutants
image size: 1200x1594

Why won't this pink stuff stop growing in my bathroom?
image size: 1200x675
Serratia Marcescens Under The Microscope🔬 — Steemit
image size: 1530x693

Serratia Marcescens Bacteria Gram-negative Rod-shaped Bacteria Stock Illustration 1036394281 | Shutterstock
image size: 1500x1101

In 1950, the U.S. Released a Bioweapon in San Francisco
image size: 1280x1280

Spatial-temporal profiling of prodiginines and serratamolides produced by endophytic Serratia marcescens harbored in Maytenus serrata | Scientific Reports
image size: 1200x1382

Mechanisms of Bacterial (Serratia marcescens) Attachment to, Migration along, and Killing of Fungal Hyphae | Applied and Environmental Microbiology
image size: 1280x784

Serratia Marcescens Bacteria Gram-negative Rod-shaped Bacteria Stock Illustration 1039928716 | Shutterstock
image size: 1500x1101

Pathology Outlines - Serratia species
image size: 1484x1200

Swabbed my phone case. Colony looked like a pink whitehead pimple. Maybe Serratia marcescens? : r/microbiology
image size: 2291x2581

The Rcs stress response system modulates Serratia marcescens induced inflammation and bacterial proliferation in a rabbit keratitis model | bioRxiv
image size: 1280x1259

Serratia Marcescens Bacteria Gram-negative Rod-shaped Bacteria Stock Illustration 1041439837 | Shutterstock
image size: 1500x1101

Serratia marcescens - Quip Labs
image size: 1017x1024

Pathology Outlines - Serratia species
image size: 1300x1419

\
image size: 1000x1000

Serratia Marcescens On Nutrient Agar Mixed Stock Photo 1914642613 | Shutterstock
image size: 1500x1113

Serratia Marcescens Bacteria, Sem #1 Tapestry by Scimat - Science Source Prints
image size: 851x1000

Pic of the Day: Serratia marcescens Serratia marcescensgrown on TSA for 48 hrs. at 37 degree's C then held at room temp for 24 hrs. Serratia marcescens is circular, mucoid and has
image size: 1080x764
Serratia marcescens : Free Download, Borrow, and Streaming : Internet Archive
image size: 3264x2176

Serratia Marcescens is a Species of Rod-shaped Gram-negative Bacteria. Stock Photo - Image of health, infection: 125527802
image size: 1600x1157

Research buzz: UW-Stout professor, students identify bacterium that may kill honey bees | All In Wisconsin
image size: 2100x1547

A Complicated Case of Vertebral Osteomyelitis by Serratia Marcescens | Cureus
image size: 986x941

Serratia Marcescens Red Rod-shaped Bacteria Package Stock Photo 2009395718 | Shutterstock
image size: 1500x1101

Serratia marcescens is a catalase-positive, weakly lactose fermenting, and gram-negative bacillus. It produces prodigiosin, a pale pink or dark red pigment. Clinical syndromes are often associated with recent instrumentation/procedure, and manifest as
image size: 1080x1080

Mechanisms of Bacterial (Serratia marcescens) Attachment to, Migration along, and Killing of Fungal Hyphae | Applied and Environmental Microbiology
image size: 1280x631

Serratia Marcescens is a Species of Rod-shaped Gram-negative Bacteria. Stock Photo - Image of cell, chemical: 125527812
image size: 1600x1157
i\u003eSerratia marcescens\u003c/i\u003e [IMAGE] | EurekAlert! Science News Releases
image size: 1440x960

American Society for Microbiology - Geometric Growth Several species of bacteria and fungi were used to create this geometric pattern. Red colors are produced by the pigmented bacteria, Serratia marcescens. Occasionally, inanimate
image size: 1224x918
What is Pink Mold: Causes and Removal Tips
image size: 1280x853

Colonies Of Prodigiosin Producing Bacterium Serratia Marcescens Spread On An Agar Plate Stock Photo - Download Image Now - iStock
image size: 1024x819

Serratia marcescens, Gram stain, OIO. Why do some appear more rounded (pointed cell) than elongated? : r/microbiology
image size: 1290x1221
Serratia marcescens and Escherichia coli isolated from soft tissue infection. Serratia marcescens produces a red pigment, prodigiosin. Prodigiosin has antimicrobial properties, potentially giving Serratia a competitive advantage against other bacteria ...
image size: 1200x900

Serratia marcescens - Magapor USA
image size: 1280x720

Serratia Marcescens Bacteria, Sem #1 Shower Curtain by Scimat - Science Source Prints
image size: 1000x1000

Serratia Marcescens is a Species of Rod-shaped Gram-negative Bacteria. Stock Photo - Image of color, cell: 125160428
image size: 1600x1157

Two babies killed by infection linked to 'contaminated washing up liquid' in hospital sparking urgent recall
image size: 5760x3840

Serratia marcescens - Sandra Black
image size: 1500x1500

Environmental Isolate Case Files: Serratia marcescens - Microbiologics Blog
image size: 1024x805

🦠 Serratia marcescens – When Bacteria Turns Red 🔴 🔬 Ever seen red colonies on a Petri dish and thought it was blood? Think again! This striking color belongs to Serratia marcescens,
image size: 1537x2048

Serratia marcescens in the intestine of housefly larvae inhibits host growth by interfering with gut microbiota | Parasites \u0026 Vectors
image size: 1200x675

Serratia marcescens causing recurrent superficial skin infections in an immunosuppressed patient - Drummond - 2023 - Skin Health and Disease - Wiley Online Library
image size: 2128x1182

Serratia marcescens: Video, Causes, \u0026 Meaning | Osmosis
image size: 1280x720

Serratia Marcescens is a Species of Rod-shaped Gram-negative Bacteria. Stock Photo - Image of drug, chemical: 125160412
image size: 1600x1157

Serratia marcescens: Video, Causes, \u0026 Meaning | Osmosis
image size: 816x1056

A Serratia marcescens OxyR Homolog Mediates Surface Attachment and Biofilm Formation | Journal of Bacteriology
image size: 1112x1114

Serratia marcescens culture. Petri dish containing a nutrient medium that has been used to culture the bacterium Serratia marcescens. This is a facult Stock Photo - Alamy
image size: 1300x956

Serratia marcescens causing recurrent superficial skin infections in an immunosuppressed patient - Drummond - 2023 - Skin Health and Disease - Wiley Online Library
image size: 2128x2326

The possibility of using Serratia isolates for the production of biopreparations in the protection of plants against diseases and pests | Archives of Microbiology
image size: 967x872

RssAB-FlhDC-ShlBA as a Major Pathogenesis Pathway in Serratia marcescens | Infection and Immunity
image size: 1280x933

Chronic granulomatous disease | Causes, Symptoms \u0026 Treatment | Britannica
image size: 1164x1041

Frontiers | Microbial prodigiosin shows broad-spectrum bioactivity confirmed by experimental and computational analyses
image size: 1535x749

Mechanisms of Bacterial (Serratia marcescens) Attachment to, Migration along, and Killing of Fungal Hyphae | Applied and Environmental Microbiology
image size: 1758x1800

Serratia marcescens: Video, Causes, \u0026 Meaning | Osmosis
image size: 816x1056

Serratia marcescens as an Uncommon Cause of Infection Following Craniectomy: A Case Report and Literature Review
image size: 2010x2048

Culturing Serratia marcescens for microbiology class
image size: 1000x1000

Serratia Marcescens Bacteria, Sem Coffee Mug by Scimat - Science Source Prints
image size: 1200x850

The fliR gene contributes to the virulence of S. marcescens in a Drosophila intestinal infection model | Scientific Reports
image size: 1575x2006

Pigment production in Serratia marcescens : r/microbiology
image size: 1200x1186
Frontiers | Transcriptional factor OmpR positively regulates prodigiosin biosynthesis in Serratia marcescens FZSF02 by binding with the promoter of the prodigiosin cluster
image size: 1200x801

MicroRounds (Day 958): \
image size: 1000x1000

\
image size: 1500x1000

Pink Mold: Don't Let Its Pretty Color Fool You! | Moisture Master Pros
image size: 1280x720

Serratia Marcescens: Characteristics, Pathogenesis \u0026 Clinical Manifestations | Bacteriology Lectures You Can Try This Out (IiBVG46Z9C)
image size: 980x980

Serratia marcescens Red Pigment Bacteria Glyph Two Color 67636573 Vector Art at Vecteezy
image size: 1920x2880

Serratia has dark history in region / Army test in 1950 may have changed microbial ecology
image size: 685x1447

Serratia marcescens and its role in Pink breast milk and upper GI bleeding in an infant: a Tanzanian case report | BMC Infectious Diseases
image size: 1105x1390

Coloured scanning electron micrograph (SEM) of Serratia marcescens, Gram-negative, facultative anaerobic prokaryote (bacterium). Serratia species occu Stock Photo - Alamy
image size: 979x1024

Antibiotic Sensitivity Test Of Serratia Marcescens Stock Photo - Download Image Now - Antibiotic Resistant, Agar Jelly, Antibiotic - iStock
image size: 2048x2048

Serratia marcescens · iNaturalist
image size: 1200x1131

Serratia Marcescens Bacteria, Sem #1 Face Mask by Scimat - Science Source Prints
image size: 2048x1152

Serratia md Esherichia coli species Micro B-1.pptx
image size: 2128x810
Cutaneous Serratia marcescens infection in two dogs - Park - 2024 - Journal of Small Animal Practice - Wiley Online Library
image size: 1200x1200

An impressive display of Serratia marcescens from shower grout sample cultured on our, 21-40S53 SDA plate. #microbiologymonday #microbiology #microbiologylab #bacteria #lablife #agar #agarplate #whatgrowsovertheweekend #serratiamarcescens #Moltox
image size: 1280x1220

An IgaA/UmoB Family Protein from Serratia marcescens Regulates Motility, Capsular Polysaccharide Biosynthesis, and Secondary Metabolite Production | Applied and Environmental Microbiology
image size: 1200x816

Spatial-temporal profiling of prodiginines and serratamolides produced by endophytic Serratia marcescens harbored in Maytenus serrata | Scientific Reports
image size: 1280x854

What is Pink Mold: Causes and Removal Tips
image size: 771x1280

Mechanisms of Bacterial (Serratia marcescens) Attachment to, Migration along, and Killing of Fungal Hyphae | Applied and Environmental Microbiology
image size: 2560x1707

Opportunistic infection by Serratia marcescens - Medizinonline
image size: 1024x934

How to Clean Pink Shower Slime So It Never Comes Back - Homeowner Answers
image size: 1000x988
Bacteria colors — Akna Márquez
image size: 1162x1200

Serratia marcescens and Escherichia coli isolated from soft tissue infection. Serratia marcescens produces a red pigment, prodigiosin. Prodigiosin has antimicrobial properties, potentially giving Serratia a competitive advantage against other bacteria ...
image size: 685x1334

Pangenome of Serratia marcescens strains from nosocomial and environmental origins reveals different populations and the links between them | Scientific Reports
image size: 986x1195

A Sixty-Nine-Year-Old Female With Serratia marcescens Infection | Cureus
image size: 980x980

Serratia marcescens Red Pigment Bacteria 67387402 Vector Art at Vecteezy
image size: 1200x1200

Serratia Marcescens Bacteria, Sem #1 Throw Pillow by Scimat - Science Source Prints
image size: 1200x868

Gut Fungus Suspected in Crohn's Disease | Scientific American
image size: 1424x1970

A case of pulmonary Serratia marcescens granuloma radiologically mimicking metastatic malignancy and tuberculosis infection - Joyutpal Das, Benjamin Layton, Harriet Lamb, Nicola Sinnott, Bernard C Leahy, 2015
image size: 1000x1000

Serratia Bacteria Cultures | Carolina Biological Supply
image size: 2048x1152

Serratia md Esherichia coli species Micro B-1.pptx
image size: 1200x800

Week 4: Biochromes - Revica
image size: 2253x1970

ShlA toxin of Serratia induces P2Y2- and α5β1-dependent autophagy and bacterial clearance from host cells - Journal of Biological Chemistry
image size: 980x980

Serratia marcescens Red Pigment Bacteria Line Two Color 67431581 Vector Art at Vecteezy
image size: 780x1040
Discover more galleries
- January 25, 2025 Cuff Sleeve Tattoos /2025-01-25/cuff-sleeve-tattoos
- October 2025 Hip Hop Wallpapers 3d /2025-10/hip-hop-wallpapers-3d
- March 2025 제25차 개정안 /2025-03/je25ca-gaejeongan
- November 2025 Immagini Lambro Monza Spyder /2025-11/immagini-lambro-monza-spyder
- November 24, 2025 Descargar Fondos De Pantalla De Patinaje Artístico /2025-11-24/descargar-fondos-de-pantalla-de-patinaje-artistico
- August 2025 톰 히들스턴 헨리 V 키스 /2025-08/tom-hideulseuteon-henri-v-kiseu
- February 16, 2025 Cobra Sleeve Tattoos /2025-02-16/cobra-sleeve-tattoos
- May 22, 2025 Pagina Inicial 187 Clique Aqui /2025-05-22/pagina-inicial-187-clique-aqui